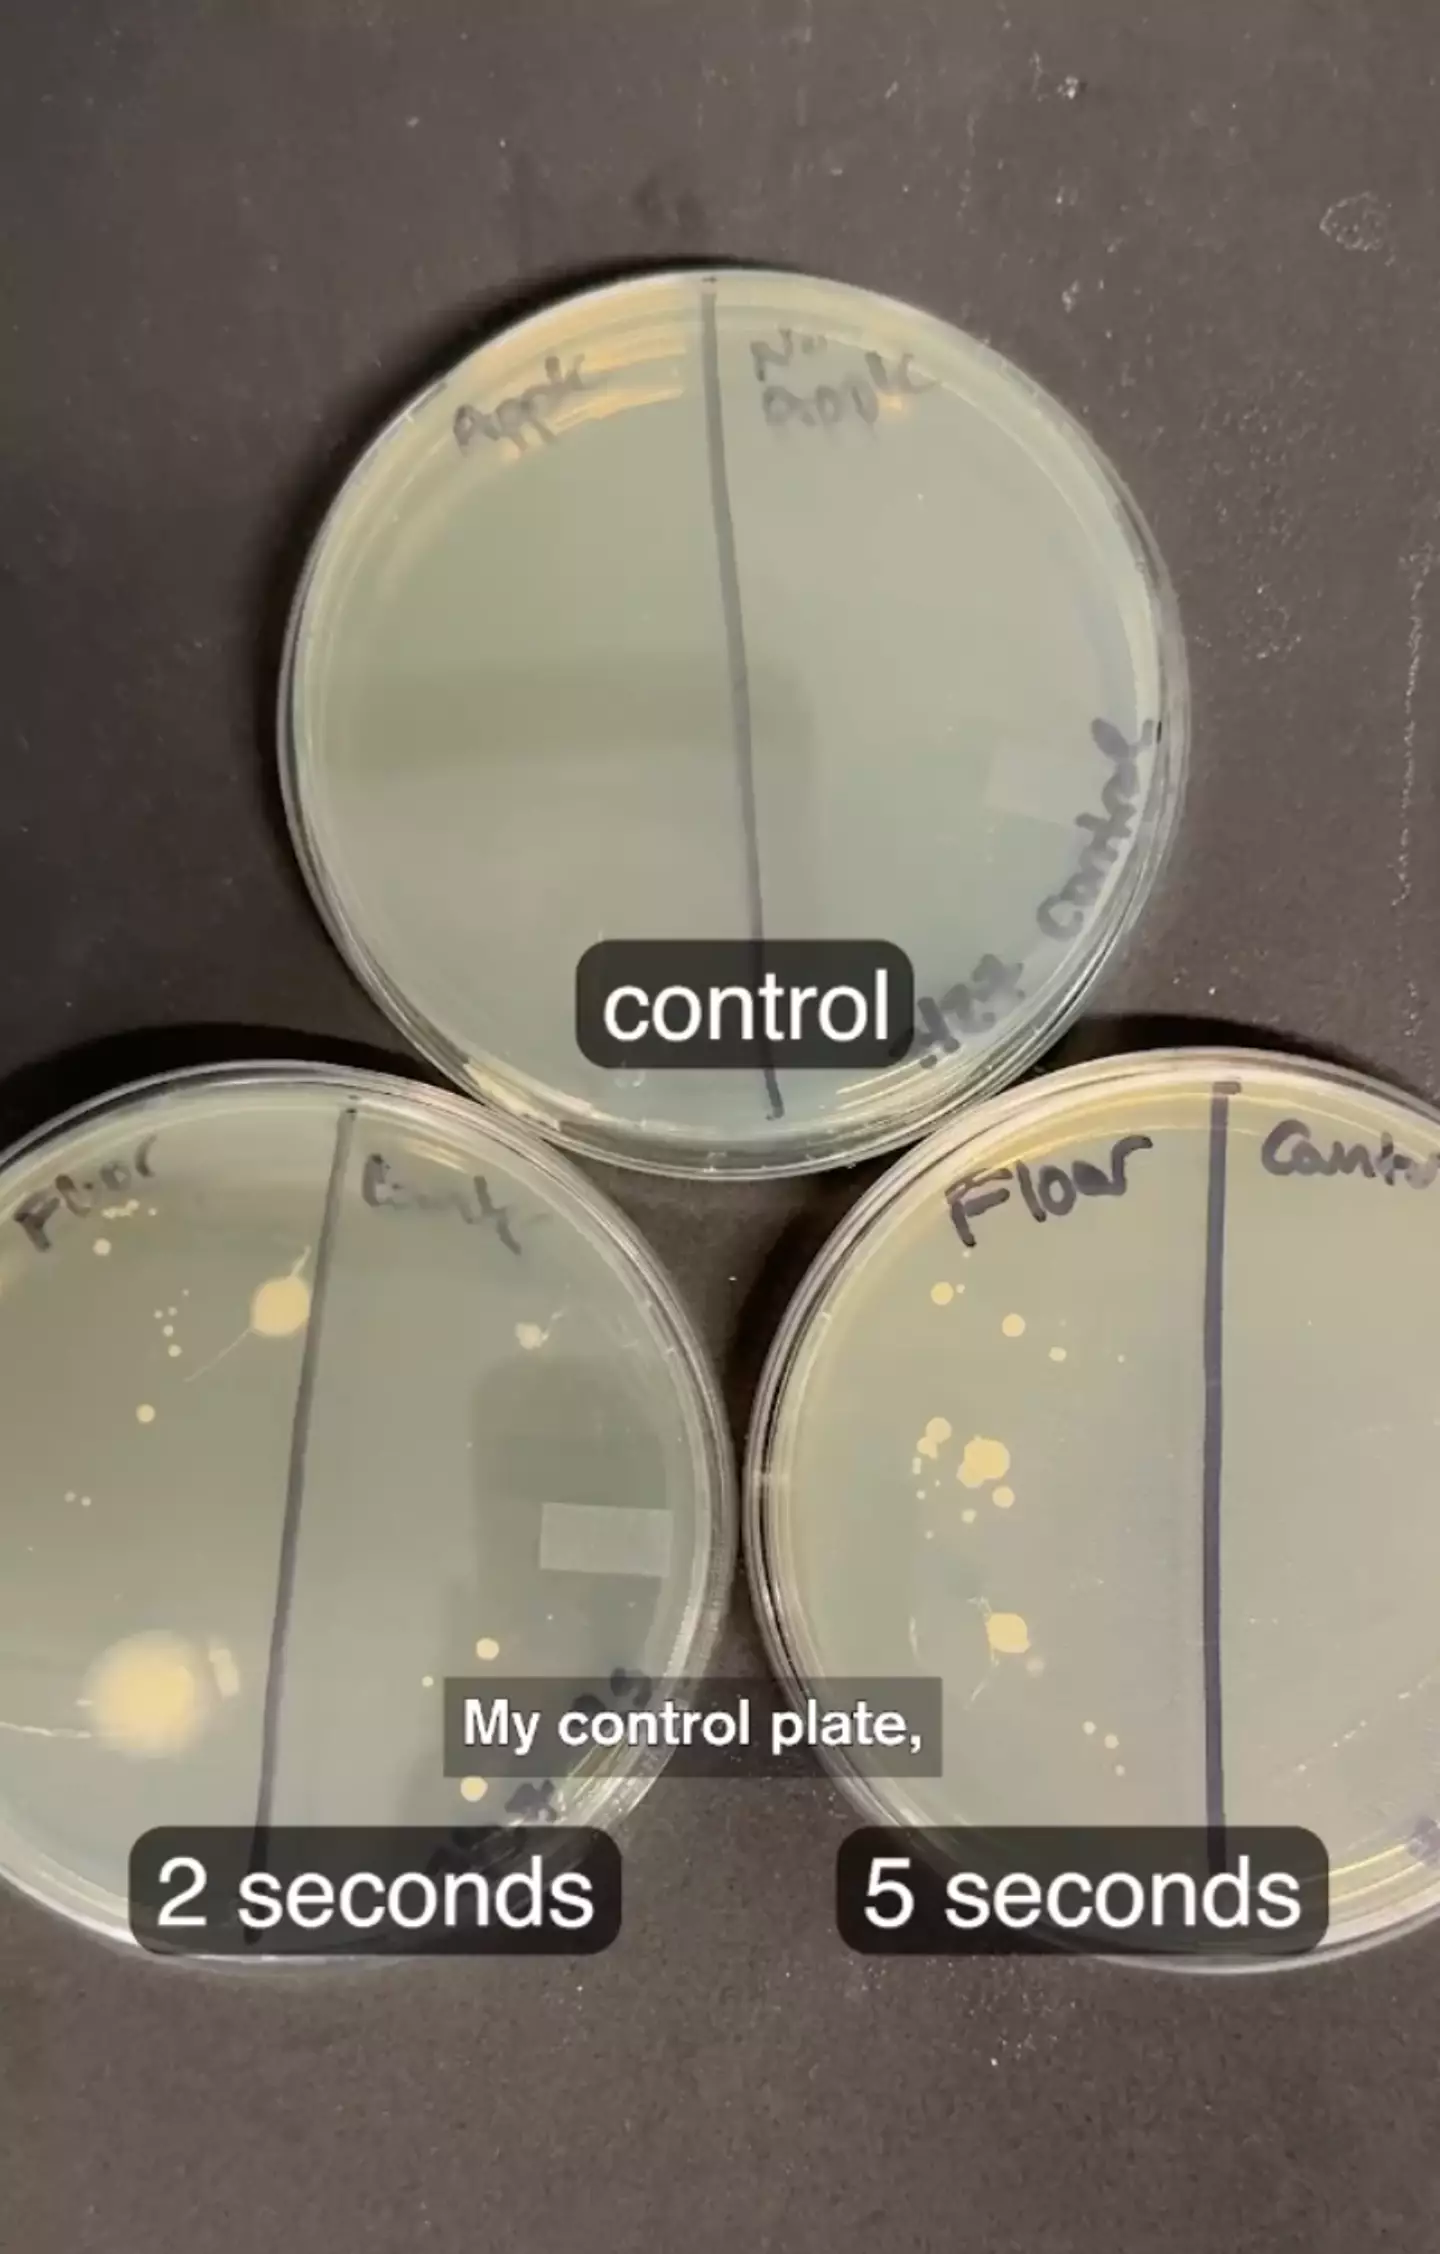
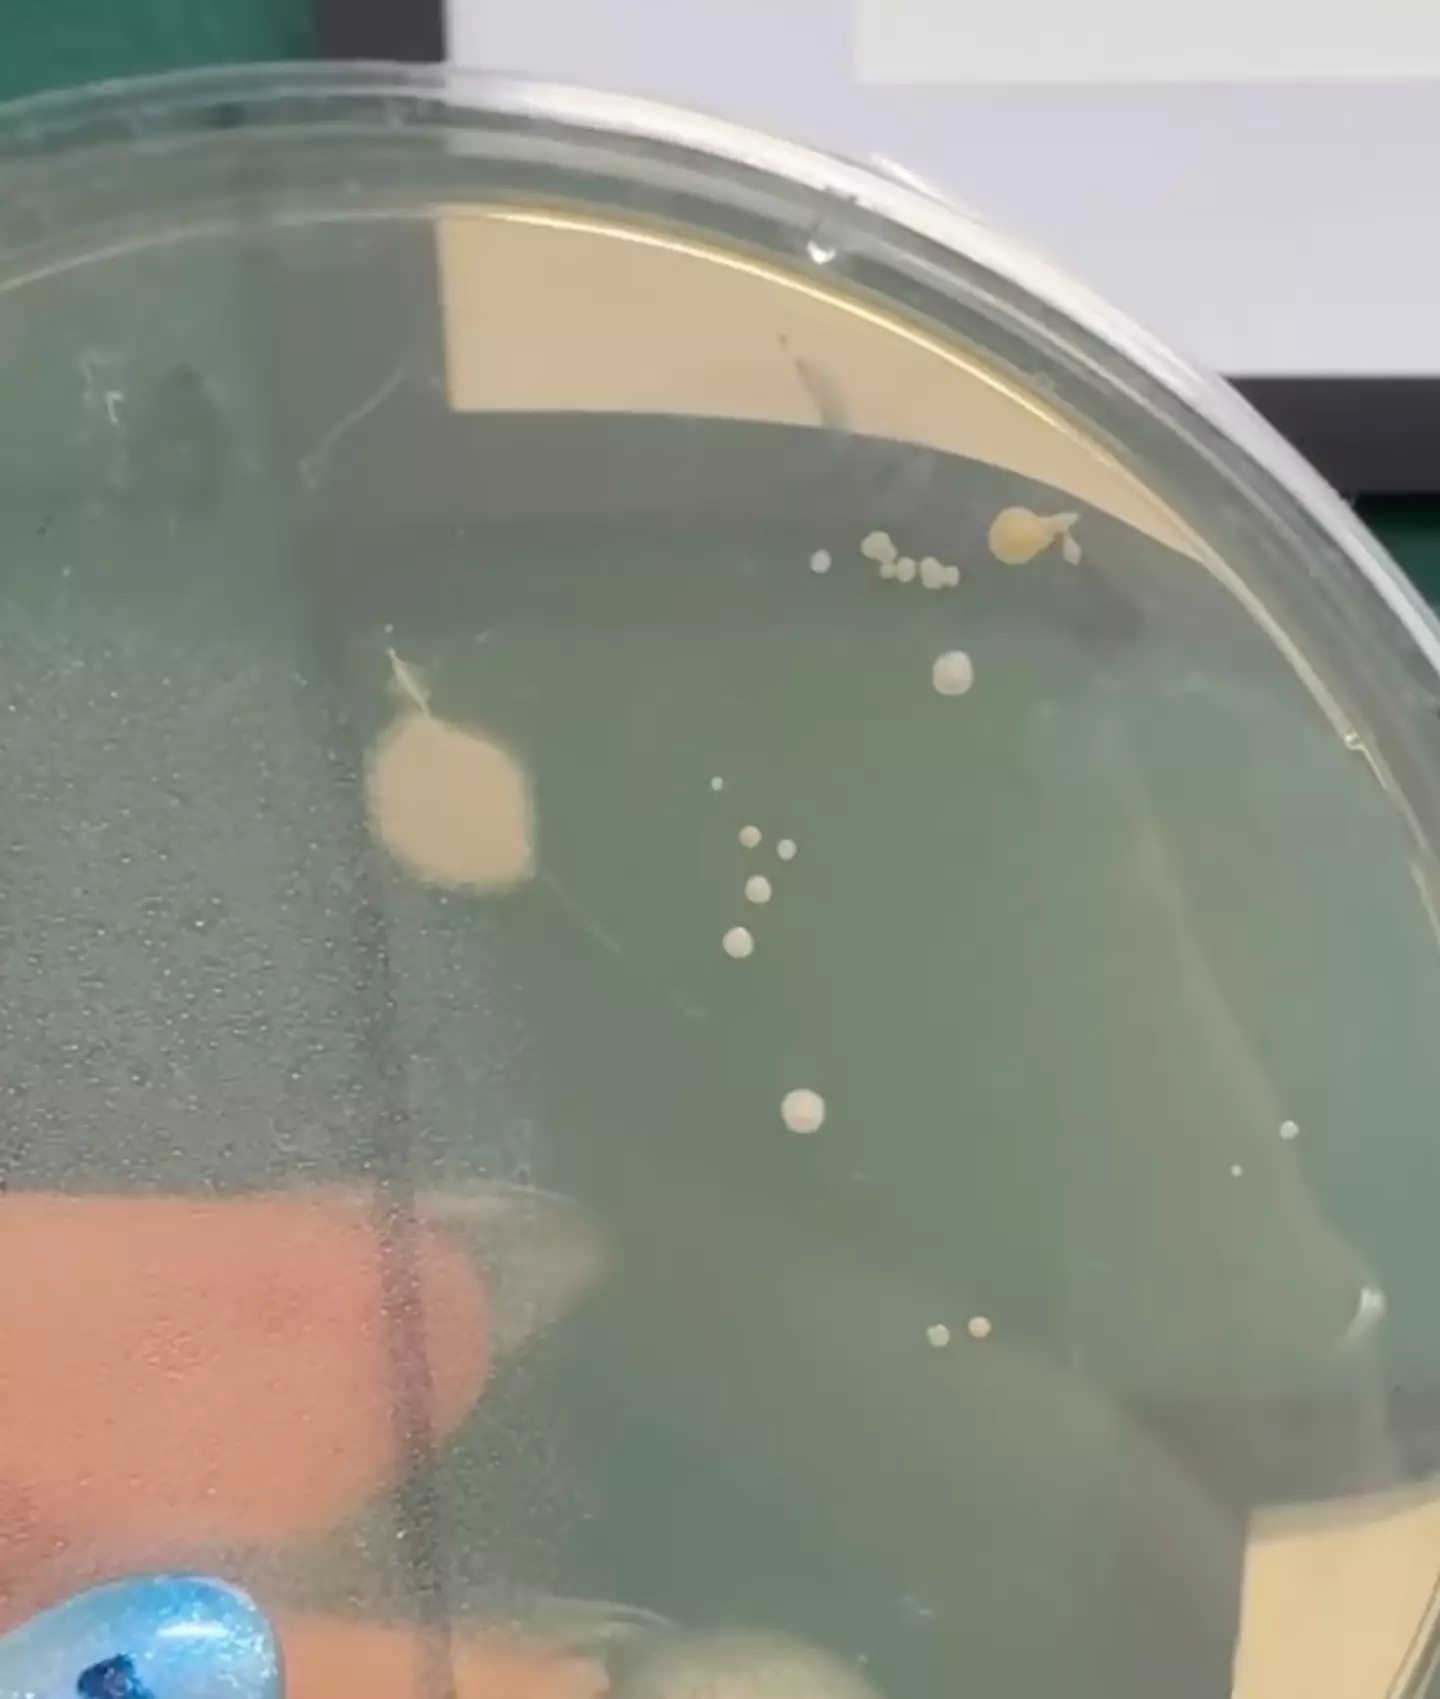

A social media scientist who claimed she 'tested out' the notorious 'five-second rule' has lifted the lid on the stomach-curdling results of her experiment.
Taking to Instagram on behalf of the Museum of Science, genetics PhD student and video producer Alex Dainis showed the graphic aftermath of dropping chunks of fruit onto the ground and leaving them for varying amounts of time.
For those unfamiliar with the food-based superstition known as the 'five second rule', basically, if a dropped ingredient hits a seemingly clean floor, you have five seconds to pick it up before dangerous microbes become attached to it.
As part of her study - which is detailed in the new online video - Dainis dropped five pieces of apple onto the ground.
Advert
"I picked half of them up after two seconds to test what would happen if you picked food up almost immediately," she explained. "And then I picked up half of them after five seconds.
"I then pressed each piece onto an agar plate to see what would grow."
The scientist went on to add that she also stamped pieces of apple straight from the cutting board - that hadn't touched the floor - as her control factor.
Advert
"If the five-second rule is real," Dainis continued. "Then the pieces of apple I picked up almost immediately should show less bacterial growth than the ones where the apple sat on the floor for a full five seconds."
Shockingly, she went on to reveal that the results of her study proved that the 'five-second rule' does 'not hold up'.
"The plates where I picked up the apple pieces after two seconds looked pretty much the same as the plates where I picked the apple pieces up after five seconds," she explained.
Showing her followers the results, tiny blobs of bacteria could be seen having grown to the same extent in both cases.
Advert
The plate containing the apple that hadn't touched the floor at all, however, showed no trace of bacteria.
"So, it's not like these microbes were coming from my cutting board," Dainis went on to note. "Or the apple itself.
"So, even after just two seconds, I probably wouldn't be eating that piece of apple that fell on the floor."
Advert
The results of the experiment subsequently sparked quite the discussion in the comments of the post, with some wondering what they indicated about food hygiene on a more practical basis.
"Ok but what’s the worst that can happen to you if you eat it?" one asked. "Signed, a mom who just helplessly watched her toddler eat something that fell on the floor."
Another said: "I think the 5 -econd rules applies better for items that are dry vs wet. Chips/fries vs apples."
Others claimed they'd continue abiding by the long-rumoured rule.
Advert
"Great info. We don’t thrive in a sterile world," a third penned. "Adversity in all things is necessary, and the strongest survive.
"I’ll still keep priming my gut biome with the occasional 5-second rule morsels."
Another went on to say: "The point is those bacteria won’t do anything in your stomach if you have a good immune system :) so no point panicking. Just wash it and eat it."
Topics: Science, Food and Drink, Life, Real Life, True Life